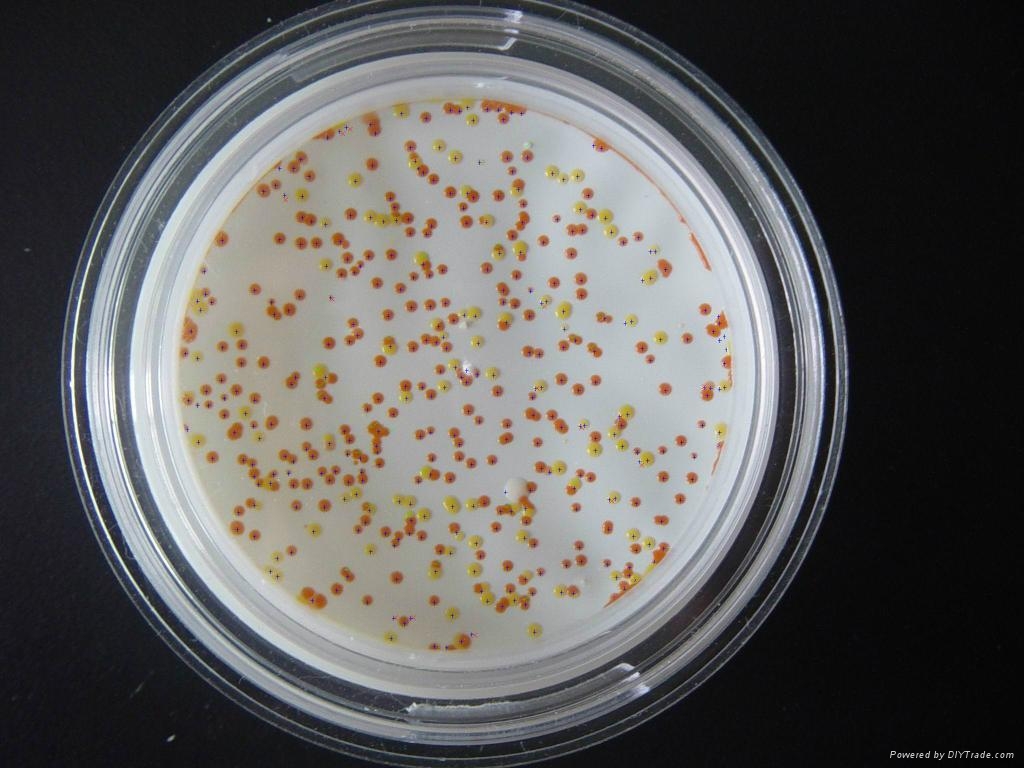
aureus)也称"金葡菌",隶属于 a target="_blank" href="/item/葡萄

金葡菌

aureus)也称"金葡菌",隶属于 a target="_blank" href="/item/葡萄
图片尺寸661x349
金葡菌肺炎的完整转归——鹤壁人医 汪涛
图片尺寸600x800
aureus)也称"金葡菌",隶属于葡萄球菌属,是革兰氏阳性菌
图片尺寸472x472
aureus)也称"金葡菌",隶属于 a target="_blank" href="/item/葡萄
图片尺寸400x400
aureus)也称"金葡菌",隶属于 a target="_blank" href="/item/葡萄
图片尺寸1024x768
金黄色葡萄球菌:金黄色葡萄球菌病因及发病机制
图片尺寸465x361
首个耐药金葡菌快速检测获准
图片尺寸400x308
疾控话健康|细菌那些事儿——金黄色葡萄球菌|革兰|金葡菌_网易订阅
图片尺寸660x660
金黄色葡萄球菌显色平板 用于金葡菌的分离和鉴定 法国科玛嘉
图片尺寸800x800
俊豪老师讲肺病之金黄色葡萄球菌的贪欲史
图片尺寸640x373
金黄色葡萄球菌
图片尺寸659x471
金黄色葡萄球菌mrsa
图片尺寸1024x602
金黄色葡萄球菌临床分离株erma,ermb,ermc和msra基因检测分析
图片尺寸426x450
金黄色葡萄球菌
图片尺寸1280x853
金黄色葡萄球菌
图片尺寸958x1278
我养的金葡菌大小不均一不能用于发文章想请教一下怎样避免这个问题
图片尺寸675x900
金黄色葡萄球菌具有阻碍某些抗菌药物的抗性策略
图片尺寸500x347
耐甲氧西林的金黄色葡萄球菌.据百度百科
图片尺寸300x400
金黄色葡萄球菌的图片
图片尺寸2816x2112
关于金黄色葡萄球菌和沙门氏菌的问题
图片尺寸1944x2592